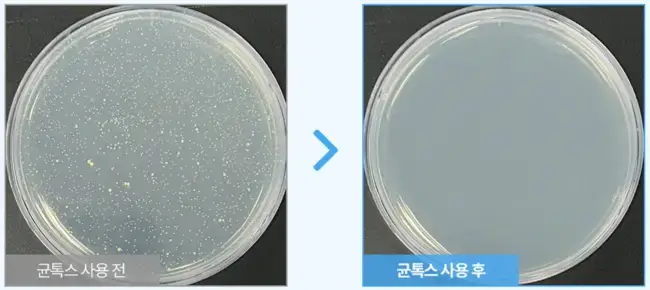

균톡스에 대해 궁금하신 가요? 발톱무좀이 있으면 발톱이 기형으로 보기도 흉하고 건강에도 안 좋습니다. 뿐만 아니라, 이러한 문제성 발톱은 공동으로 쓰는 물건에 의해 전염이 된다고 하니 빠른 시일내 치료하는것이 좋습니다.
오늘 소개해 드리는 이 제품은 발톱 무좀 때문에 고민하시는 분들에게 좋은 소식이 될 거 같은데요.
여기서는 균톡스 효과 사용법, 그리고 궁금증까지 정리해 드리겠습니다.
균톡스, 뭐죠?

균톡스는 닥터 피드백 브랜드가 만든 제품으로, 문제성 발톱을 개선하기 위한 솔루션입니다. 이 제품은 각질을 깊숙이 흡수하여 발톱의 원인균을 제거하고, 측백나무잎 추출물 등의 자연 재료로 만들어져 안전합니다. 각질을 뚫는 강력한 흡수력을 가진 균톡스는 하루 한 방울로 3개월 정도 사용하면 문제성 발톱을 개선할 수 있습니다. 제품은 30ml 용액이 병에 들어있으며, 편리한 사용을 위해 뚜껑에는 스포이드가 달려 있습니다. 만족하지 않으면 100% 환불 정책을 시행하고 있는데, 이는 제조사의 제품에 대한 자신감의 표출로 볼수 있습니다.
균톡스 성분, 작용
균톡스의 주요 성분은 축백나무잎추출물, 흰버드나무껍질추출물, 소나무잎추출물 3가지인데요. 어떤 작용을 하는지 아래에서 알아 볼게요.
측백나무잎추출물
측백나무잎추출물은 산화 방지, 피부보호, 보습, 유연화 등의 효과로 문제성 발톱 개선에 도움이 될수 있으며, 항균 효능이 있어 자연 방부제로 사용됩니다.
흰버드나무껍질추출물
흰버드나무껍질추출물에는 살리실산이 많이 함유돼 각질을 부드럽게 하고 각질제거를 도와 세포의 주기를 도와주며, 문제성 발톱 개선에 도움을 줍니다.
소나무잎추출물
소나무잎추출물에는 피톤치드의 주성분인 테르펜이 7~12%나 들어 있어 무좀, 곰팡이성 피부염, 여드름 등에 효과적이라고 합니다.
하이드로젠퍼 옥사이드
그런데, 위 성분만으로는 무좀을 없앨수는 없겠죠. 그래서 무좀을 없에는데 결정적 역할을 하는 뭔가가 있을거 같아 찾아봤는데요.

바로, '하이드로젠퍼 옥사이드'라는 거였어요.
이 성분은 과산화 수소라고 알고 있으면 되는데요. 무좀이 있는 피부에 바르면 무좀균을 제거하는 효과가 있다고 합니다.
전성분표에 기재된 순서는 가장 많이 들어 있는 것부터 적기 때문에, 균톡스에는 이 성분이 전성분표의 3번째에 들어 있어, 상당한 함량이 함유돼 있음을 확인하실수 있어요. (위 전성분표 참조)
이 외, 다이프로필렌 글라이콜은 다른 성분의 흡수를 도와주고, 보습역할을 하고, 글리세린은 피부에 수분 공급을 해주며, 글리세레스-26도 보습, 폴리솔베이트 20도 다른 성분의 흡수를 도와줍니다. 또, 클로페네신은 항균작용, 하이드록시아세토페논은 산화 방지, 부틸렌글라이콜은 보습에 도움을 줍니다.
효과
균톡스의 효과는 각질 및 무좀 균을 제거하고 보습 및 항균 작용으로 새로운 발톱이 나오기까지 환경을 조성하는것으로 판단할수 있습니다.
효과에 대한 검증의 하나로, 균톡스 사용전후 곰팡이균 성장도를 측정해 봤는데요. 다음과 같이 나타났다고 하는데요.
사용 방법
균톡스 사용방법은 어렵지 않은데요.
1. 먼저 발을 깨끗이 씻은 후, 제품 포장에 들어 있는 네일파일로 문제성 발톱을 다듬습니다. (이렇게 하면 더 흡수가 잘되기 때문임)
2. 문제성 발톱 안쪽에서 바깥쪽으로 균톡스 용액을 떨어 뜨립니다.
3. 시간적 여유가 있을때는 거품을 확인하고 내용물이 스며들때까지 그대로 놔둡니다. 그 뒤 손으로 문질러 흡수시켜줍니다.
4. 시간적 여유가 없다면, 2분정도 되면 손으로 문질러 흡수시켜 줍니다.
5. 제품을 바른 손은 깨끗하게 씻습니다.
6. 하루 두번 아침, 저녁으로 발라줍니다.
자주 묻는 질문 정리
제품 1개면 얼마나 사용할수 있나요?
하루 2번씩 매일 사용 기준 40~50일 정도 분량입니다.
얼마나 사용하면 효과 있나요?
피부에 나타나는 증상의 경우, 1~2달 꾸준히 사용했을때 효과가 나타나며, 새손발톱이 자라는 시간이 있으므로, 문제성 발톱을 개선하기 위해서는 3개월 정도는 지나야 합니다. 아침 저녁으로 꾸준히 발라주실 것을 추천 드립니다.
손톱에 사용해도 되나요?
발톱 뿐만 아니라, 손톱에도 동일하게 사용하실수 있습니다. 문제성 손톱의 원인은 발톱의 경우와 유사하다보 보시면 됩니다.
구매 방법 및 가격
균톡스 구매 방법은 홈페이지나 온라인에서 모두 구매 가능하고, 가격도 26,900원으로 동일합니다. 아래 링크에서는 더 저렴하게 구매 하는 방법, 혜택도 가능한 걸로 보이니, 방문하셔서 혜택을 확인해 보시기 바랍니다.
맺으며
오늘은 무좀 등으로 인한 문제성 손 발톱 솔루션인 균톡스에 대해 알아 봤는데요. 무좀은 곰팡이가 피부의 각질층에 감염을 일으켜 발생되는 질환으로, 경미한 경우는 연고로도 치료가 된다고 합니다.
하지만, 아주 심한 경우에는 항진균제를 복용해야 한다고 하므로, 이 제품으로 활용을 해 보시고, 더 이상 차도가 없으시다면 전문의와 상담을 통해 완치하는 방법을 찾아 보시기 바랍니다.
오늘 포스팅이 도움되길 바라고요. 효과적인 무좀관리로 더 건강한 피부 관리, 손발톱관리 해보시기 바랍니다.
'건강' 카테고리의 다른 글
| 건강의영웅 산양삼 원료 효능 가격 먹는법 주의사항 정리 (0) | 2024.06.01 |
|---|---|
| 다모아 질유산균 내돈내산 효과 있어? 가격 사용법 (0) | 2024.05.29 |
| 알티지오메가31000 뉴트리모어 프리미엄 식물성 초임계 왜 추천? (0) | 2024.05.27 |
| 몸드름균차단 바디워시가 효과 있을까요? 내돈내산 성분 사용법 (0) | 2024.05.10 |
| 어스빌폴리코사놀 뭐가 달라? 혈행 효능 복용법 부작용 필수 체크 (0) | 2024.05.06 |
